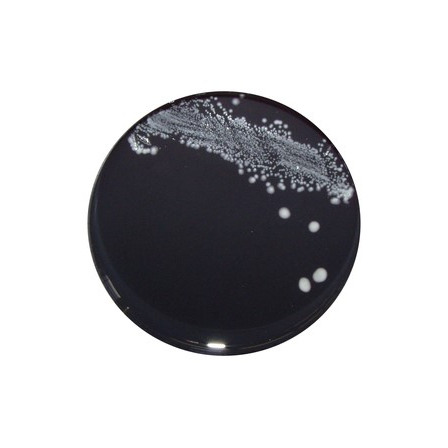

カンピロバクター選択分離「CCDA培地」
調製操作が容易!安定性も良い◎
弊社では、カンピロバクター検査に使用するさまざまな培地をご用意しております。 臨床材料からカンピロバクターを検出するには、 CCDA培地やスキロー培地など種々の選択分離培地が利用されています。 しかし、数年前より糞便中のESBLs産生菌等の耐性化した共雑菌が検査の支障となることが多く報告され、問題となっています。 弊社では、ESBLs産生菌等の発育抑制を強化した「CCDA寒天培地(SEL)」を開発しました。 【CCDA培地(SEL)】 ◆大腸菌をはじめとする雑菌の発育を強く抑制します。 ◆雑菌抑制能の向上により。糞便検体の選択分離が容易となりました。 ◆背景が黒なので発育した集落とのコントラストが明瞭です。 【CCDA培地(Ox)】 ◆OXOID社のCCDA培地は血液を使わないカンピロバクター選択分離培地です。 ◆選択制に優れ、他のグラム陰性桿菌の発育や遊走を強く抑制します。 ◆食品・環境・臨床と幅広い範囲の材料に利用できます。 ◆血液を使わないので調製操作が簡便です。
基本情報
細菌性食中毒においてカンピロバクター食中毒は発生件数が最も多く、食中毒全体でもノロウィルスに次ぐ発生件数となっております。 食品検査ではカンピロバクターを選択増菌培養後に選択培地で分離します。カンピロバクターを疑うコロニーが出現した場合 は、さらに確認試験をおこなうため、判定まで約4~5日間を費やします。 また、カンピロバクターは微好気状態を好むので専用のガス発生器が必要です。 増菌培養には「71531 カンピロバクター用ストマック袋」を使用すると微好気状態を作れます。
価格帯
納期
用途/実績例
詳細は下記カタログをご覧いただくか、お気軽にお問い合わせください。
カタログ(3)
カタログをまとめてダウンロードおすすめ製品
取り扱い会社
関東化学は1944年(昭和19年)の設立以来、総合試薬メーカーとして、試薬、電子材料、臨床検査薬、化成品の4つの分野で厳しい品質管理体制の下、競争力の高い製品を開発し続けています。